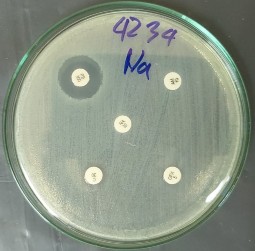
B2 Kiểu hình kháng kháng sinh chung của các chủng Salmonella spp Kiểu hình kháng 1
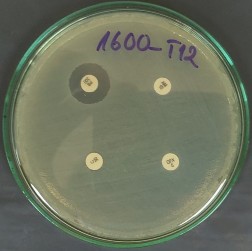
B2 Kiểu hình kháng kháng sinh chung của các chủng Salmonella spp Kiểu hình kháng 2

146. Wannaprasat W., Padungtod P., Chuanchuen R., 2011. Class 1 integrons and virulence genes in Salmonella enterica isolates from pork and humans. International Journal of Antimicrobial Agents. 37: 457-461.
147. Wassenaar T. M., Jun S. R., Wanchai V., Patumcharoenpol P., Nookaew I., Schlum K., Leuze M. R. and Ussery D. W., 2017. Insights from comparative genomics of the genus Salmonella. DOI: 10.5772/67131.
148. White P. A., McIver C. J., and Rawlinson W. D., 2001. Integrons and gene cassettes in the Enterobacteriaceae. Antimicrobial Agents and Chemotherapy. 45: 2658-2661.
149. WHO (World Health Organization), 2016, 2017. Critically important antimicrobials for human medicine.
150. Wold B., Myers R. M., 2008. Sequence census methods for functional genomics. Nature Methods. 5(1): 19-21.
151. Wong V. K., Baker S., Parkhill J., 2015. Phylogeographical analysis of the dominant multidrug-resistant H58 clade of Salmonella Typhi identifies inter and intracontinental transmission events. Nature Genetics. 47(6): 632-639.
152. Yang B., Qu D., Zhang X., Xi M., Sheng M., Zhi S., Meng J., 2010. Prevalence and characterization of Salmonella serovars in retail meats of marketplace in Shaanxi, China. International Journal of Food Microbiology. 141: 63-72.
153. Yang H., Byelashov O. A., Geornaras I., Goodridge L. D., Nightingale K. K., Belk K. E., Smith G. C., and Sofos J. N., 2010. Characterization and transferability of class 1 integrons in commensal bacteria isolated from farm and nonfarm environments. Foodborne Pathogens and Disease. 7: 1441-1451.
154. Zankari E., Hasman H., Kaas R. S., Seyfarth A. M., Agerso Y., Lund O., Larsen M. V., Aarestrup F. M., 2013. Genotyping using whole genome sequencing is a realistic alternative to surveillance based on phenotypic antimicrobial susceptibility testing. Journal of Antimicrobial Chemotherapy. 68(4): 771-777.
155. Zou W., Frye J. G., Chang C. W., Liu J., Nayak R., 2009. Microarray analysis of antimicrobial resistance genes in Salmonella enterica from preharvest poultry environment. Journal of Applied Microbiology. 107(3): 906-914.
156. Xu Z., Li L., Shi L., Shirtliff M. E., 2011. Class 1 integron in Staphylococci. Molecular Biology Reports. 38(8): 5261-5279.
PHỤ LỤC
PHỤ LỤC A: VẬT LIỆU VÀ PHƯƠNG PHÁP
A1. Các dạng sản phẩm đại diện cho từng nhóm thực phẩm
Trứng | Thịt | Thủy hải sản | Rau, củ, quả | |
Sản phẩm | - Trứng gà, vịt, cút tươi - Sản phẩm từ trứng (trứng muối, trứng bắc thảo,…) | - Thịt heo, bò, gà tươi - Thịt và sản phẩm thịt (nem chua, chà bông, lạp xưởng, chả chiên, chả lụa,…) | - Thủy hải sản tươi (cá, mực, tôm,…) - Sản phẩm chế biến từ thủy hải sản (cá hấp, tôm khô, mắm,…) | - Rau củ quả tươi - Rau quả muối, rau quả khô |
Có thể bạn quan tâm!
-
Nhóm Gen Liên Quan Đến Kháng Nhóm Β-Lactam -
Nhóm Gen Liên Quan Đến Kháng Nhóm Sulfonamide/trimethoprim -
Nghiên cứu tính kháng kháng sinh ở mức độ phân tử của Salmonella spp. phân lập từ thực phẩm tại thành phố Hồ Chí Minh - 16 -
Nghiên cứu tính kháng kháng sinh ở mức độ phân tử của Salmonella spp. phân lập từ thực phẩm tại thành phố Hồ Chí Minh - 18 -
Nghiên cứu tính kháng kháng sinh ở mức độ phân tử của Salmonella spp. phân lập từ thực phẩm tại thành phố Hồ Chí Minh - 19
Xem toàn bộ 155 trang tài liệu này.
STT | Môi trường nuôi cấy, hóa chất, thuốc thử | Hãng/Code | |
1 | Môi trường tăng sinh không chọn lọc | Buffer Pepton Water (BPW) | Merck/1.07228 |
2 | Môi trường tăng sinh chọn lọc | Rappaport-Vassiliadis medium with soya (RVS Broth) | Merck/1.07700 |
3 | Muller-Kauffmann tetrathionate- novoniocin (MKTTn Broth) | Merck/1.05878 | |
4 | Modified semi-solid Rappaport- Vassiliadis (MSRV agar) | Merck/1.09878 | |
Môi trường thạch chọn lọc | |||
5 | Xylose Lysine Deoxychonate agar (XLD agar) | Merck/1.05287 | |
6 | MLCB agar | Oxoid/CM0783 | |
7 | Thạch dinh dưỡng | Nutrient agar (NA) | Merck/1.05450 |
8 | Triple sugar/iron agar (TSI agar) | Merck/1.03915 | |
9 | Ure agar | Merck/1.08492 | |
10 | Môi trường sinh hóa | Lysine decarboxylation medium (LDC) | Oxoid/CM0308 |
11 | ONPG | Oxoid/DD13 | |
12 | Tryptone/tryptophan medium | Scharlau/02-418 | |
13 | Thuốc thử Kovacs | Merck/1.09293 | |
14 | Kháng huyết thanh O | Difco/222641 | |
15 | Kháng huyết thanh | Kháng huyết thanh H | Difco/224061 |
16 | Kháng huyết thanh Vi | Difco/228271 | |
17 | Kit thử sinh hóa | API 20E | Biomérieux/20100 |
A2. Môi trường, hóa chất, thuốc thử dùng phân lập Salmonella spp.
A3. Thành phần môi trường BHI và Mueller Hinton
Thành phần | Hàm lượng (g/l) | Ghi chú | |
Sản phẩm thủy phân từ mô tế bào động vật bằng enzym | 10,0 | ||
Canh thang BHI | Bột não bê | 12,5 | pH 7,4±0,2 ở 25oC |
Bột tim bò | 5,0 | ||
Glucose | 2,0 | ||
Natri clorua | 5,0 | ||
Dinatri hydrophosphat, khan (Na2HPO4) | 2,5 | ||
Dịch thủy phân mô động vật bằng enzym | 300,0 | pH 7,3±0,1 ở 25oC | |
Mueller- Hinton | Dịch thủy phân casein bằng enzym | 17,5 | |
Tinh bột, có thể hòa tan | 1,5 | ||
Thạch | 17,0 |
A4. Môi trường thử nghiệm sinh hóa
* Thạch TSI (Triple Sugar Iron Agar)
Cấy ria trên bề mặt nghiêng của thạch và cấy đâm sâu xuống đáy. Ủ ở 37oC trong (24±3) giờ. Diễn giải các thay đổi trong môi trường như sau:
a) Cấy đâm sâu
glucose dương tính (lên men glucose) glucose âm tính (không lên men glucose) sinh hydro sulfid sinh khí từ glucose |
b) Bề mặt nghiêng của thạch
lactose và/hoặc sucrose dương tính (lên men lactose và/hoặc sucrose) | |
- màu đỏ hoặc không đổi màu | lactose và sucrose âm tính (không lên men lactose hoặc sucrose) |
Phần lớn các chủng cấy Salmonella điển hình thể hiện tính kiềm (màu đỏ) trên bề mặt nghiêng của thạch và tính axit (màu vàng) có sinh khí (bọt khí), (với khoảng 90% trường hợp) sinh hydro sunfua (thạch bị đen) khi cấy đâm sâu.
* Thạch urê
Cấy ria trên bề mặt nghiêng của thạch. Ủ ở 37oC/24 giờ. Nếu phản ứng dương tính thì urê được phân giải thành amoniac, làm phenol đỏ chuyển thành màu hồng và sau đó chuyển thành màu đỏ anh đào sẫm. Phản ứng thường xuất hiện sau 2 đến 4 giờ. Các chủng cấy Salmonella điển hình không phân giải urê, do đó thạch urê sẽ không đổi màu.
* Môi trường LDC (L-Lysin Decarboxylase)
Cấy ngay phía dưới bề mặt của môi trường lỏng. Ủ ở 37oC trong (24±3) giờ. Môi trường đục và có màu đỏ tía sau khi ủ cho thấy phản ứng dương tính. Màu vàng cho thấy phản ứng âm tính. Phần lớn các chủng cấy Salmonella điển hình có phản ứng LDC dương tính.
A5. Diễn giải các phép thử sinh hóa của Salmonella spp.
Chủng Salmonella | |||||
S. typhi | S. paratyphi A | S. paratyphi B | S. paratyphi C | Khác | |
Sinh axit từ glucose | + | + | + | + | + |
Sinh khí từ glucose | - | + | + | + | + |
Sinh axit từ lactose | - | - | - | - | - |
Sinh axit từ sucrose | - | - | - | - | - |
Sinh H2S | + | - | + | + | + |
Thủy phân ure | - | - | - | - | - |
Lyzin đã khử nhóm cacboxyl | + | - | + | + | + |
β-galactosidase | - | - | - | - | - |
Sinh indol | - | - | - | - | - |
A6. Diễn giải các kết quả các phép thử khẳng định
Tự ngưng kết | Phản ứng huyết thanh | Diễn giải | |
Điển hình | Không | Kháng nguyên O và H dương tính (và Vi dương tính nếu thử nghiệm) | Các chủng được coi là Salmonella |
Điển hình | Không | Kháng nguyên O và/hoặc H âm tính | Có thể là Salmonella |
Điển hình | Có | Không thử nghiệm vì tự ngưng kết (xem 9.5.4.2) | |
Không điển hình | - | - | Không được coi là Salmonella |
A7. Quy trình xác định typ huyết thanh chủng phân lập Salmonella spp. bằng cách ngưng kết với các kháng huyết thanh OMA và OMB đa giá
Sử dụng các kháng huyết thanh đa giá | 1.1 OMA Nếu dương tính: bước 2.1.1 Nếu âm tính: sang bước 1.2 | 1.2 OMB Nếu dương tính: bước 2.2.1 Nếu âm tính: xem chú thích a | |
Bước 2 Phân tích kháng nguyên-O | Sử dụng các nhóm kháng huyết thanh đặc hiệu-dùng cho một chủng phân lập đối với nhóm huyết thanhb | 2.1.1 O:4,5 hoặc nhóm B Nếu dương tính: bước 3.1.1 Nếu âm tính: bước 2.1.2 2.1.2 O:9 hoặc nhóm D Nếu dương tính: bước 3.1.2 Nếu âm tính: bước 2.1.3 2.1.3 O:3,10,15 hoặc nhóm E Nếu dương tính: bước 3.1.3 Nếu âm tính: bước 2.1.4 2.1.4 O:21 hoặc nhóm L Nếu âm tính: bước 2.1.5 2.1.5 O:1,2 hoặc nhóm A | 2.2.1 O:6,7,8 hoặc nhóm C Nếu dương tính: bước 3.2.1 Nếu âm tính: bước 2.2.2 2.2.2 O:13.22,23 hoặc O:13 Nếu dương tính: bước 3.2.2 Nếu âm tính: bước 2.2.3 2.2.3 O:11 |
Bước 3 Phân tích kháng nguyên-O | Sử dụng các kháng huyết thanh đơn giá - nhận biết serovar kháng nguyên-O đặc hiệu | 3.1.1 Chủng phân lập nhóm B: O:5, O:27 3.1.2 Chủng phân lập nhóm D: O:46 đối với nhóm D2 O:27 đối với nhóm D3 3.1.3 Chủng phân lập nhóm E: O:10, O:15, O:34 đối với nhóm E1 O:19 đối với nhóm E4 | 3.2.1 Chủng phân lập nhóm C O:7 đối với nhóm C1 O:8, O:61, O:20 đối với nhóm C2-3 O:14, O:24, O:25 đối với nhóm H 3.2.2 Chủng phân lập nhóm G O:22, O:23 |
Sử dụng các kháng huyết thanh đa giá | H đa giá (pha 1 và pha 2) H đa giá (pha 2) | ||
Bước 4 Phân tích kháng nguyên lông | Sử dụng các kháng huyết thanh đơn giá | H:1(1,2) → (H:2, H:5, H:6, H:7)d H:a, H:b, H:c, H:d, H:E→(H:h, H:n, H:x, Hz15)d H:G(g.m) → (H:f, H:g, H:m; H:p, H:q H:s, H:t, H:u]d H:i, H:k. H:L→(H:v, H:w, H:l,z13, H:l,z28)d H:y H:z, H:Z4→ (H:z23, H:z24, H:z32)d H:z6, H:z10, H:z29, H:z35, v.v... | |
a Trong trường hợp âm tính với cả hai kháng huyết thanh đa giá thì phân lập tiếp với
kháng huyết thanh đa giá hoặc nhóm kháng huyết thanh đặc hiệu cho phép nhận biết lên đến nhóm O:67 hoặc gửi chủng phân lập đến phòng thử nghiệm chuẩn.
b Nếu trong Bước 1 kháng huyết thanh đa giá của kháng thể khác với OMA và OMB được sử dụng thì kháng huyết thanh nhóm đặc hiệu trong bước 2 phải được sửa lại tương ứng. c Có thể bỏ qua việc sử dụng kháng huyết thanh đa giá kháng H và chọn kháng huyết thanh đơn giá tương ứng với bằng chứng phân lập serovar của nhóm huyết thanh được ước tính.
d Kháng huyết thanh trong ngoặc đơn cần thiết để nhận biết các kháng nguyên của phức
hợp kháng nguyên H tương ứng.
A8. Mức độ nhạy của vi khuẩn với một số kháng sinh (CLSI, 2018)
STT | Tên kháng sinh | Hàm lượng (g) | Kháng (R) | Trung gian (I) | Nhạy (S) |
1 | Amoxicillin- clavulanate | AMC (20/10 g) | ≤13 | 14-17 | ≥18 |
2 | Ampicillin | AMP (10 g) | ≤13 | 14-16 | ≥17 |
3 | Ceftazidime | CAZ (30 g) | ≤17 | 18-20 | ≥21 |
4 | Chloramphenicol | C (30 g) | ≤12 | 13-14 | ≥15 |
5 | Nalidixic acid | NA (30 g) | ≤13 | 14-18 | ≥19 |
6 | Ciprofloxacin | CIP (5 g) | ≤15 | 16-20 | ≥21 |
7 | Ofloxacin | OFX (5 g) | ≤12 | 13-15 | ≥16 |
8 | Gentamicin | GM (10 g) | ≤12 | 13-14 | ≥15 |
9 | Streptomycin | STR (10 g) | ≤11 | 12-14 | ≥15 |
10 | Tetracycline | TE (30 g) | ≤11 | 12-14 | ≥15 |
11 | Trimethoprim/ Sulfamethoxazole | SXT (1.25/23.75 µg) | ≤10 | 11-15 | ≥16 |
PHỤ LỤC B: KẾT QUẢ NGHIÊN CỨU VÀ THẢO LUẬN
B1. Hình ảnh kháng kháng sinh của các chủng Salmonella spp.

B2. Kiểu hình kháng kháng sinh chung của các chủng Salmonella spp.
Số lượng kháng sinh kháng | Số chủng | Tỷ lệ (%) | |
AMP, CAZ, C, NA, CIP, OFX, GM, STR, TE, SXT | 10 | 03 | 3,19 |
AMP, C, NA, CIP, OFX, GM, STR, TE, SXT | 09 | 03 | 3,19 |
CAZ, C, NA, CIP, OFX, GM, STR, TE, SXT | 01 | 1,06 | |
AMP, C, NA, CIP, OFX, GM, STR, TE | 02 | 2,13 | |
AMC, AMP, C, NA, CIP, OFX, STR, TE | 08 | 01 | 1,06 |
AMP, C, NA, CIP, GM, STR, TE, SXT | 01 | 1,06 | |
AMP, C, NA, CIP, OFX, STR, TE, SXT | 01 | 1,06 | |
AMP, C, NA, CIP, GM, STR, TE | 01 | 1,06 | |
AMC, AMP, CAZ, C, STR, TE, SXT | 07 | 01 | 1,06 |
AMP, C, NA, GM, STR, TE, SXT | 06 | 6,38 | |
AMP, NA, CIP, GM, STR, TE, SXT | 01 | 1,06 | |
AMP, CIP, GM, STR, TE, SXT | 01 | 1,06 | |
AMP, C, NA, STR, TE, SXT | 04 | 4,26 | |
AMP, C, NA, CIP, OFX, SXT | 06 | 01 | 1,06 |
AMP, C, NA, GM, STR, TE | 01 | 1,06 | |
AMP, C, NA, CIP, STR, TE | 01 | 1,06 | |
AMP, C, NA, STR, TE | 02 | 2,13 | |
AMP, C, STR, TE, SXT | 04 | 4,26 | |
AMP, C, NA, STR, SXT | 05 | 01 | 1,06 |
AMP, GM, STR, TE, SXT | 02 | 2,13 | |
AMP, C, NA, TE, SXT | 01 | 1,06 |
08 | 8,51 | ||
AMP, CIP, TE, SXT | 01 | 1,06 | |
AMP, C, STR, TE | 03 | 3,19 | |
GM, STR, TE, SXT | T 04 | 01 | 1,06 |
AMP, C, NA, SX | 02 | 2,13 | |
AMP, STR, TE, SXT | 03 | 3,19 | |
AM, NA, CIP, OFX | 01 | 1,06 | |
AMC, AMP, C, NA | 01 | 1,06 | |
AMP, STR, TE | 03 | 3,19 | |
C, STR, TE | 01 | 1,06 | |
C, TE, SXT | T 03 | 01 | 1,06 |
STR, TE, SX | 01 | 1,06 | |
AMP, C, STR | 01 | 1,06 | |
AMP, TE, SXT | 01 | 1,06 | |
NA, SXT | 01 | 1,06 | |
AMC, TE | 01 | 1,06 | |
STR, TE | T 02 | 05 | 5,32 |
TE, SX | 01 | 1,06 | |
AMP, TE | 01 | 1,06 | |
NA, TE | 01 | 1,06 | |
AMC | 01 | 1,06 | |
AMP | 01 | 1,06 | |
CAZ | 01 | 1,06 | |
C | M 01 | 02 | 2,13 |
G | 01 | 1,06 | |
STR | 01 | 1,06 | |
TE | 09 | 9,57 | |
SXT | 01 | 1,06 |
B3. Kiểu hình kháng của Salmonella spp. theo nguồn phân lập
Số chủng | Kiểu hình kháng kháng sinh | |
01 | CAZ, C, NA, CIP, OFX, GM, STR, TE, SXT | |
01 | AMC, AMP, C, NA, CIP, OFX, STR, TE | |
01 | AMP, CIP, GM, STR, TE, SXT | |
01 | AMP, C, NA, STR, TE, SXT | |
01 | AMP, C, NA, STR, TE | |
Thịt heo (38) | 01 | AMP, C, STR, TE, SXT |
05 | AMP, C, TE, SXT | |
01 | AMP, CIP, TE, SXT | |
01 | AMP, C, STR, TE | |
01 | AMP, STR, TE | |
01 | NA, SXT |





